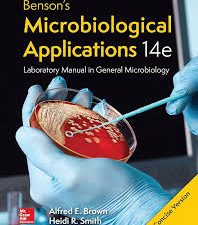
benson’s microbiological applications, laboratory manual in general microbiology, 14th edition

Herpes Simplex Virus Protocols comprises a wide range of experimental protocols that should be especially useful to new workers in herpes virology. Hopefully, it will also provide information for those with experience in the field, as well as those embarking on techniques that are new to them. Obviously the range of topics covered cannot be comprehensive, but we have tried to provide protocols dealing with those procedures that are most widely used; and we have selected expert authors accordingly. We have also tried to cover the range from the more biological in vivo maneuvers to purely molecular procedures, taking into account the topical interest in the potential use of HSV as a therapeutic tool. In this way there should be sufficient inf- mation for most procedures the average herpes virologist is likely to require– at least at this moment in time! Since the herpesviruses are a large family, we have largely based the protocols on the virus we know best–herpes simplex virus. With this as the prototype, it should be relatively easy to extrapolate and make the necessary modifications required for application to some of the other herpesviruses, especially members of the alpha group, such as PRV and EHV. It would have been an impossible task to include chapters covering the unique aspects of each known herpesvirus.
[amazon template=iframe image&asin=1617370134]
–